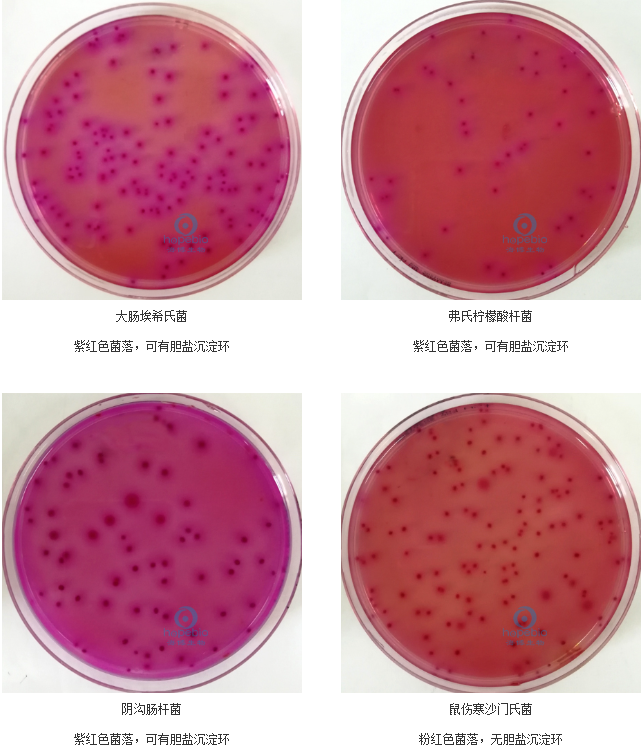
96197561.png

HBPM018 结晶紫中性红胆盐琼脂平板
发布时间 :2025-05-22 发布人:yumiaoshengwu 浏览量:递增失败!
基本信息
产品名称:结晶紫中性红胆盐琼脂平板
产品货号:HBPM018
生产厂家:青岛海博
包装规格:90mm x 10 个 / 包
产品用途:用于大肠菌群的固体平板检测。
保存温度:2-8℃避光保存
保质期:三个月
成分组成
蛋白胨:7.0g/L,提供碳氮源、维生素、生长因子和辅酶等营养物质。
酵母浸粉:3.0g/L,与蛋白胨协同作用,补充营养。
氯化钠:5.0g/L,维持培养基的渗透压平衡。
乳糖:10.0g/L,作为可发酵碳水化合物,为细菌生长提供能量。
胆盐:1.5g/L,与结晶紫共同抑制革兰氏阳性菌的生长。
结晶紫:0.002g/L,对革兰氏阳性菌如葡萄球菌、 白喉杆菌,以及绿脓杆菌、白念珠菌、表皮癣菌有杀灭作用,可抑制其生长。
中性红:0.03g/L,作为 pH 指示剂。
琼脂:15.0g/L,作为培养基的凝固剂。
产品特性
不同细菌在结晶紫中性红胆盐琼脂平板上的生长特征:
大肠埃希氏菌:呈紫红色菌落,可有胆盐沉淀环。
弗氏柠檬酸杆菌:紫红色菌落,可有胆盐沉淀环。
阴沟肠杆菌:紫红色菌落,可有胆盐沉淀环。